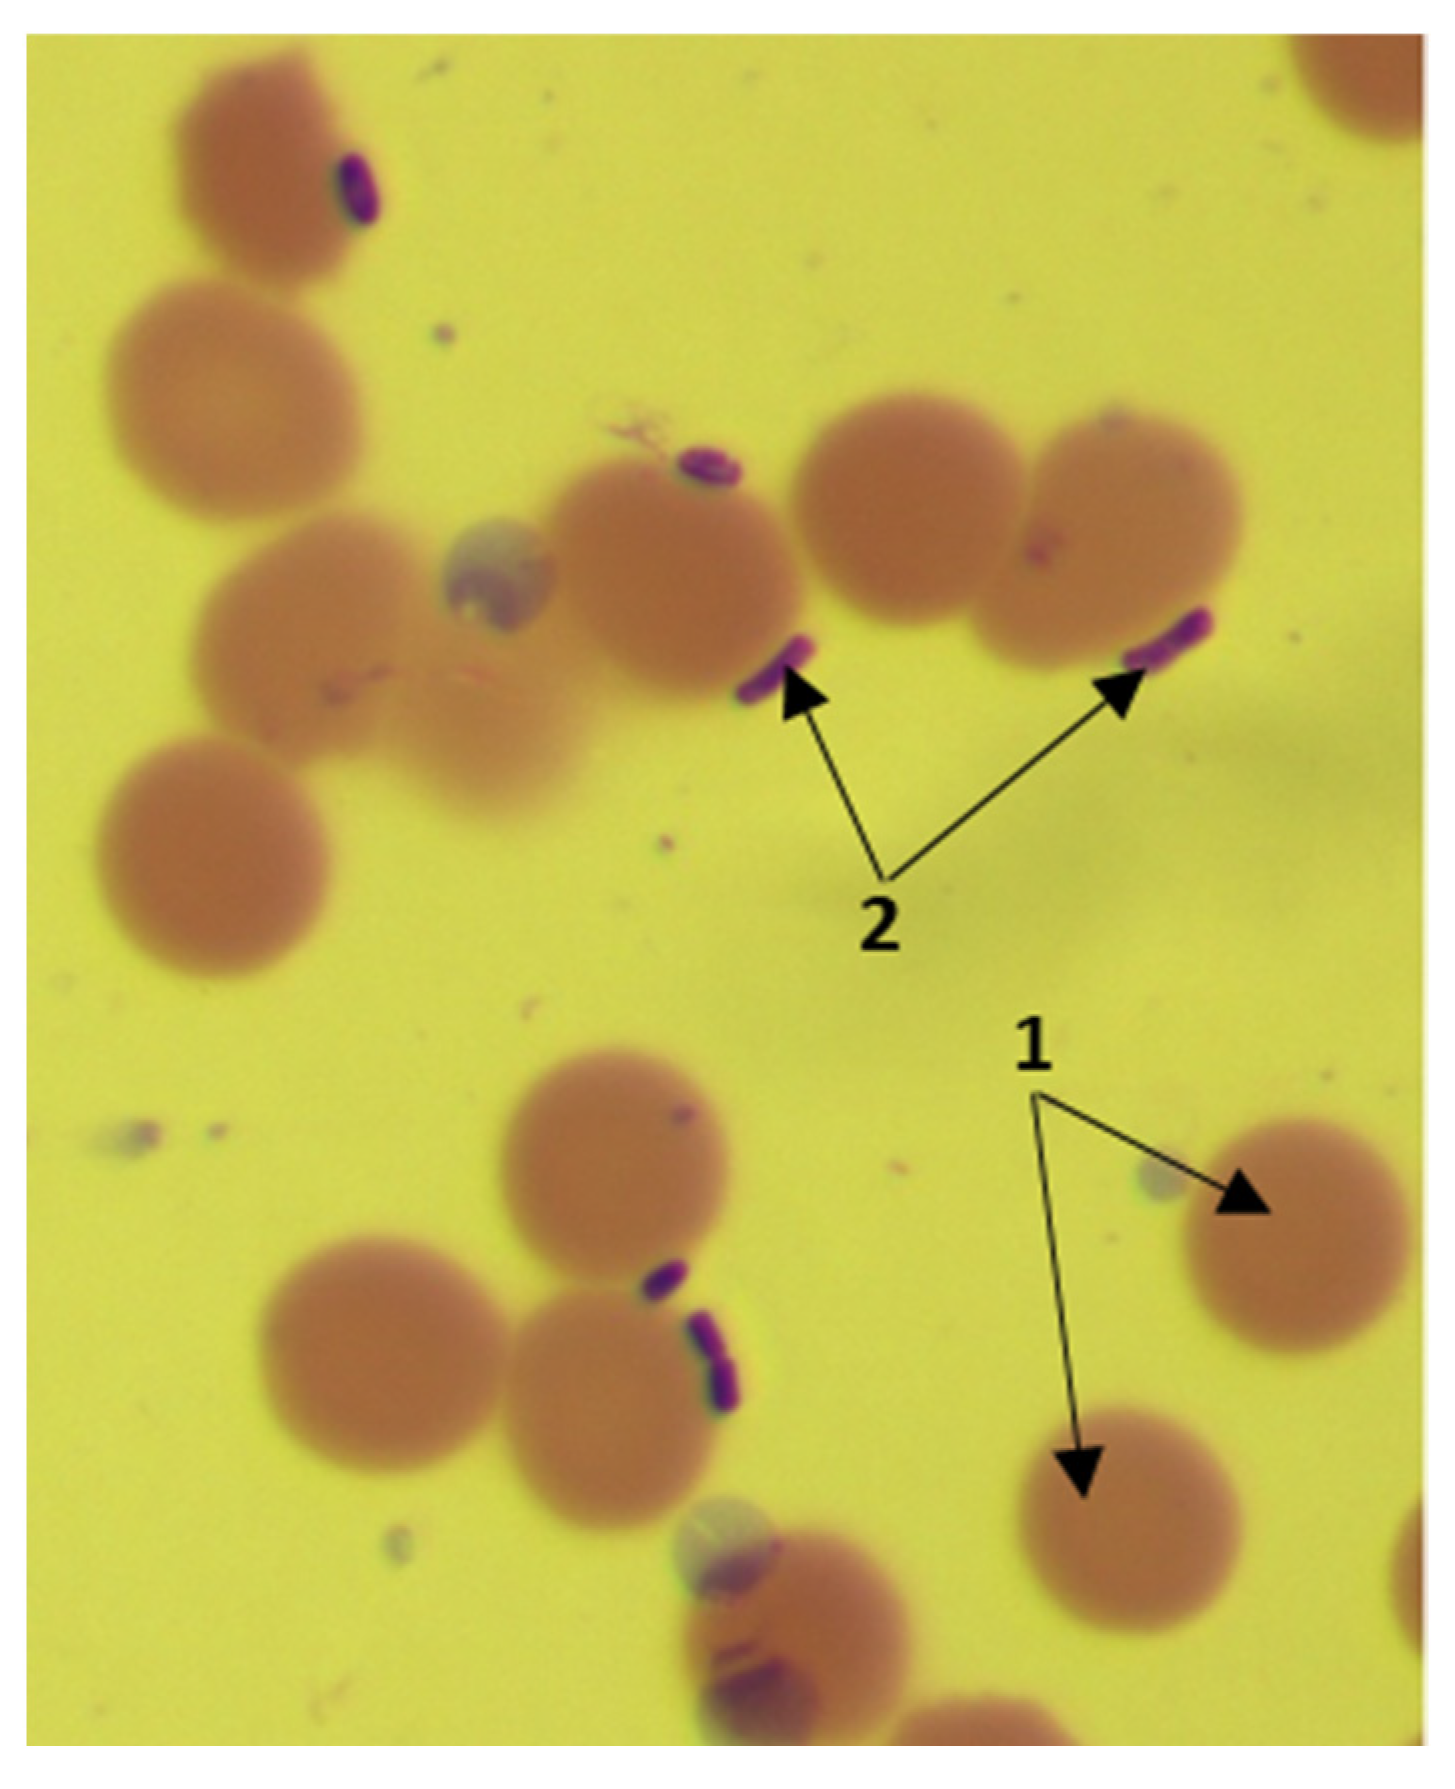
Biotech 11 00017 g002
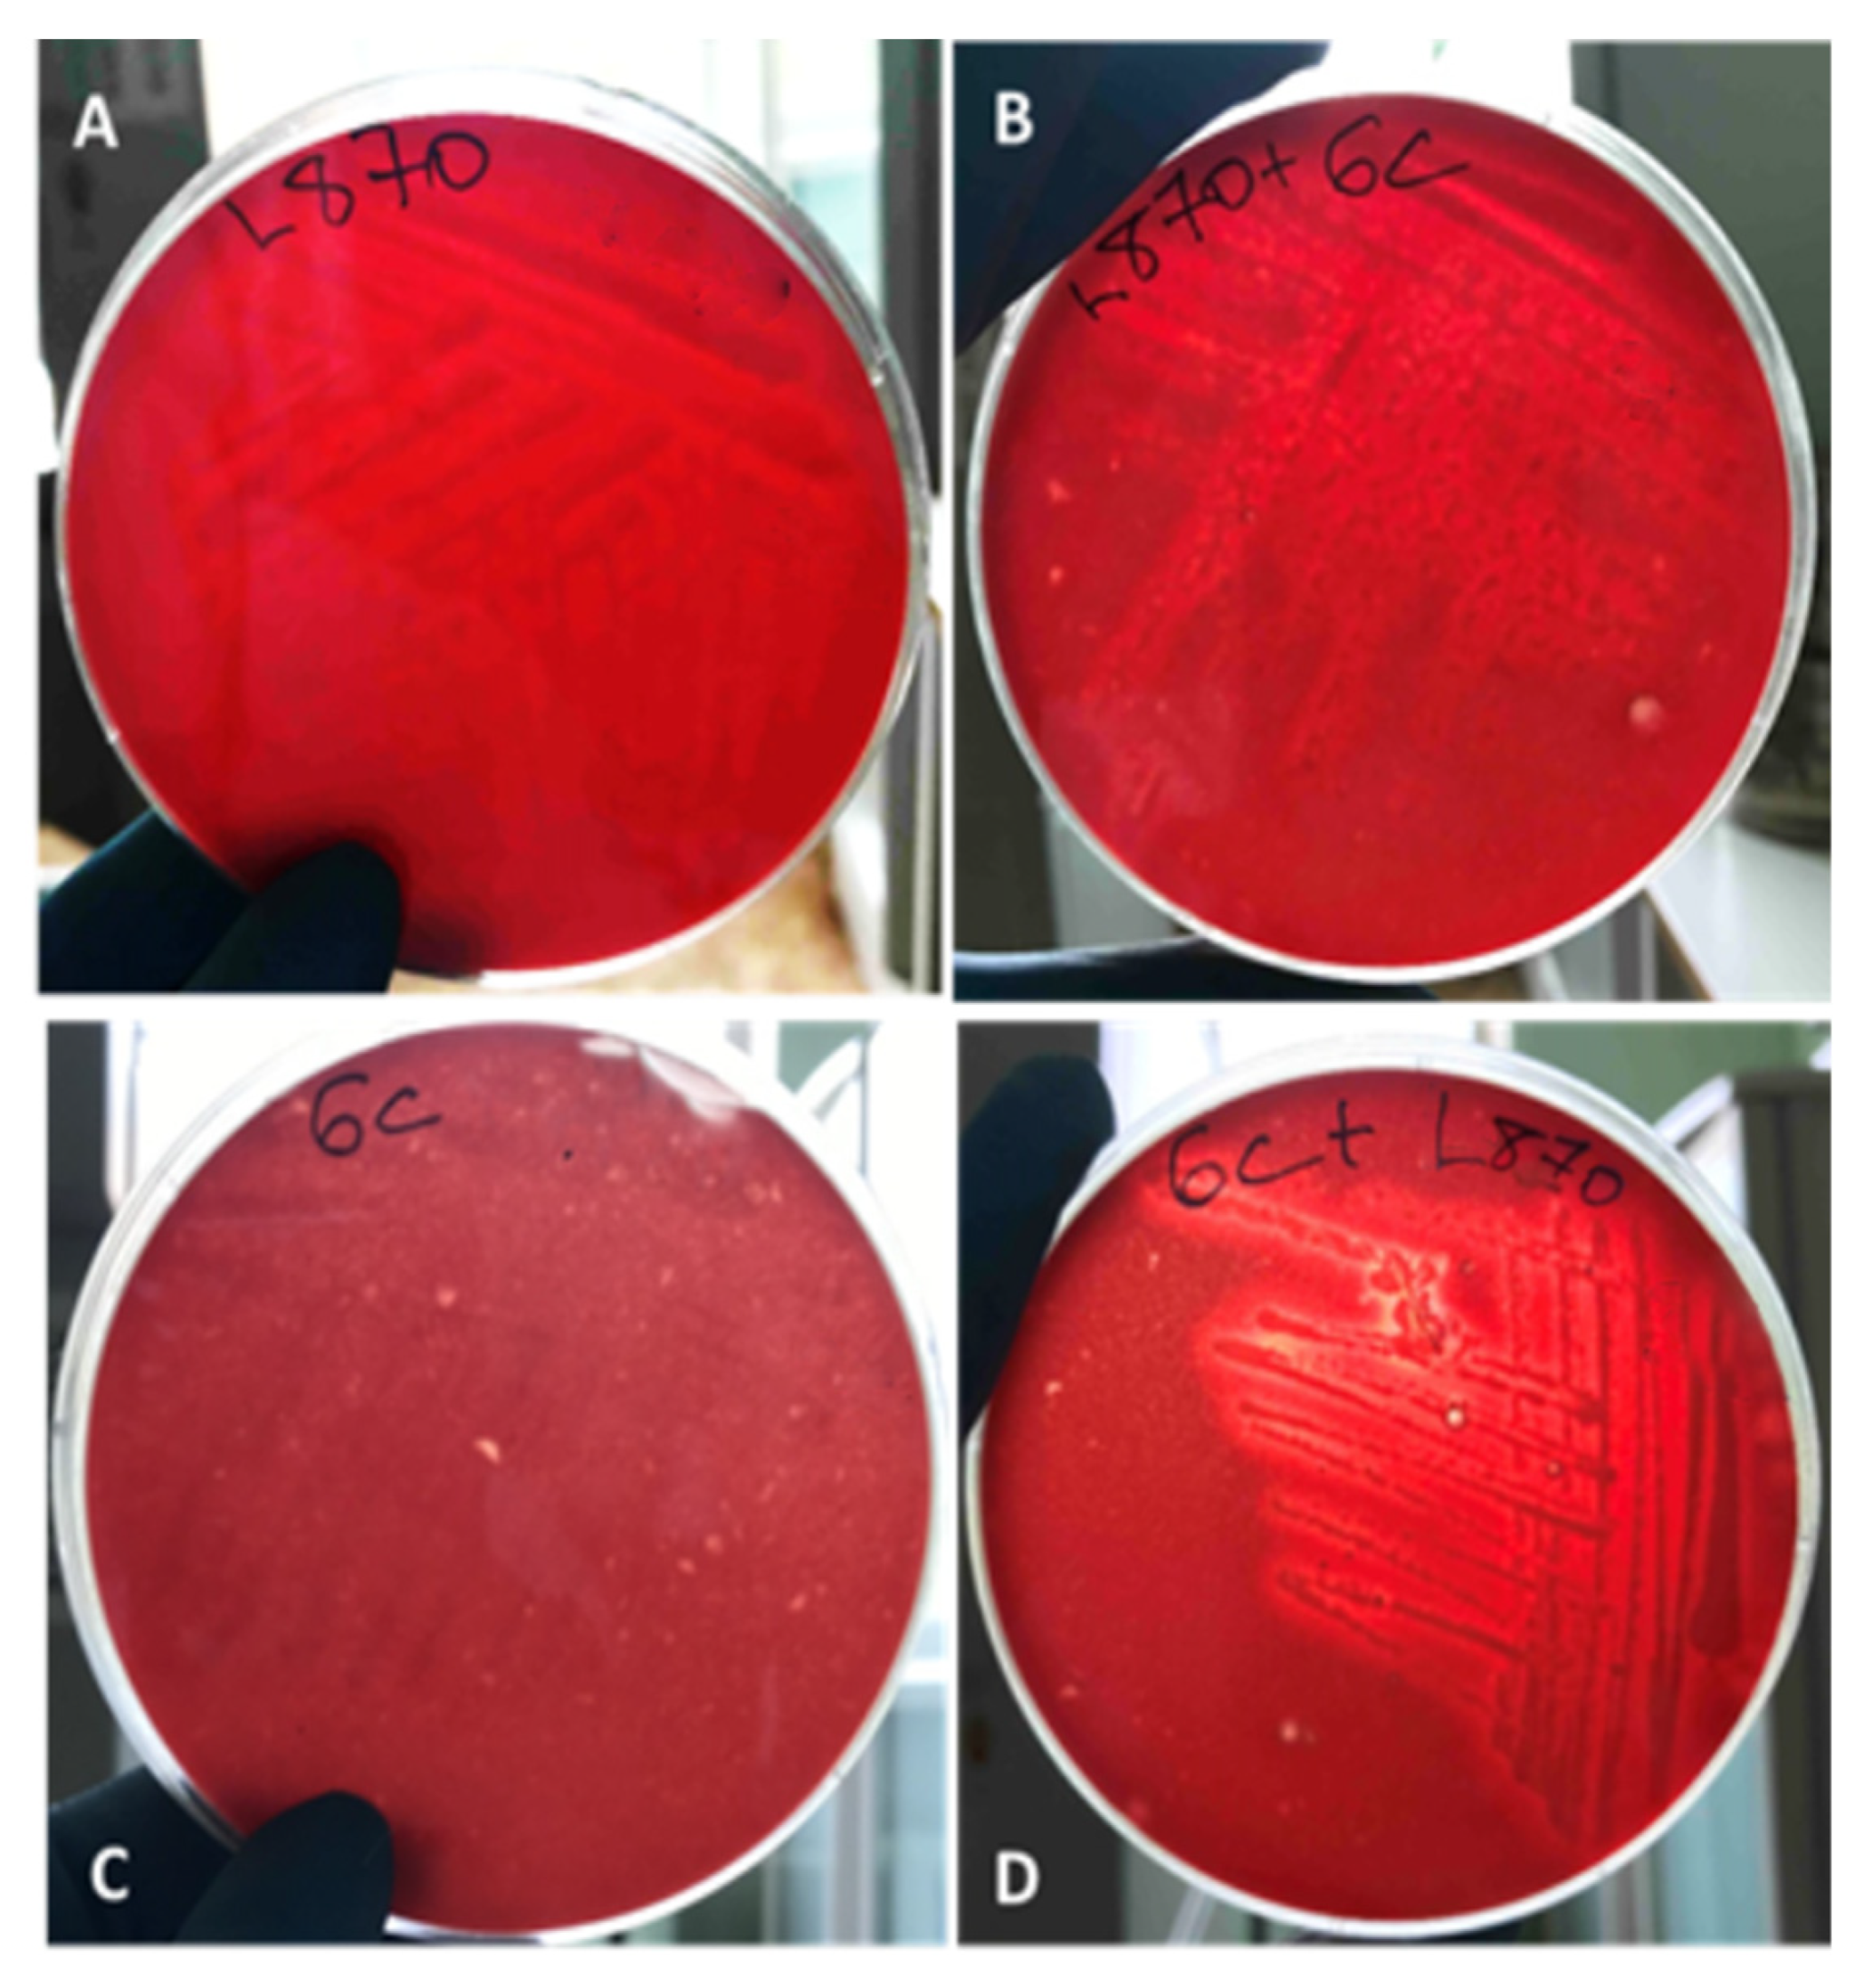
Biotech 11 00017 g003

Horizontal Transfer of Virulence Factors by Pathogenic Enterobacteria to Marine Saprotrophic Bacteria during Co-Cultivation in Biofilm
Abstract
:1. Introduction
2. Materials and Methods
2.1. Bacterial Isolates Identification and Characterization
2.2. Determination of the Ability for Mono- and Polybiofilm Formation by the Studied Strains
2.3. Study of the Pathogenicity Factors of the Studied Strains
2.4. Statistical Processing of Results
3. Research Results and Discussion
3.1. Selection of Strains for the Experiment, Their Identification
3.2. The Study of Some Properties of Pathogenicity of the Studied Strains
3.2.1. Determination of Hemolytic Activity
3.2.2. Determination of Plasma-Coagulase Activity
3.2.3. Determination of Hyaluronidase Activity
3.2.4. Evaluation of the Adhesive Properties of the Studied Bacteria
4. Conclusions
- The strain of Bacillus sp. after co-cultivation with Listeria acquired hemolytic, plasma-coagulase and hyaluronidase activities. When this saprophyte was co-cultivated with Yersinia, these pathogenic properties did not appear in it.
- Yersinia, after co-cultivation with Bacillus sp., appeared in plasma coagulase activity. The adhesiveness index of Yersinia after cultivation in a mixed biofilm with Bacillus sp. has decreased, while cultivation with the P. japonica 3P9 strain, on the contrary, led to an increase in this index in Yersinia.
- For L. monocytogenes 870, a partial ability to lyse erythrocytes and the appearance of hyaluronidase activity was noted when co-cultivated in a biofilm with Bacillus sp. The adhesiveness of Listeria in a monofilm was 3.75 ± 0.05, but after cultivation with Bacillus sp., it reached 4.1 ± 0.13. The P. japonica strain did not show potential pathogenic properties both in the monofilm and after co-cultivation with pathogens.
- The results of the experiments showed the possibility of transferring virulent properties from enterobacteria to saprotrophic marine bacteria Bacillus sp., as well as a decrease in the severity of some pathogenicity factors in the tested pathogens (and a reduction of Yersinia adhesion after cultivation in a mixed biofilm with Bacillus sp.). A change in the pathogenic properties of Listeria and Yersinia was revealed—the appearance of the ability to lyse erythrocytes, plasma-coagulase activity and an increase in the adhesiveness of Listeria after cultivation with Bacillus sp. and in Yersinia after co-cultivation with P. japonica.
Author Contributions
Funding
Data Availability Statement
Conflicts of Interest
References
- Madsen, J.S.; Burmølle, M.; Hansen, L.H.; Sørensen, S.J. The interconnection between biofilm formation and horizontal gene transfer. FEMS Immunol. Med. Microbiol. 2012, 65, 183–195. [Google Scholar] [CrossRef] [PubMed] [Green Version]
- Andryukov, B.G.; Besednova, N.N.; Zaporozhets, T.S. Mobile Genetic Elements of Prokaryotes and Their Role in the Formation of Antibiotic Resistance in Pathogenic Bacteria. Antibiot. Chemother. 2022, 67, 62–74. [Google Scholar] [CrossRef]
- Coyne, M.J.; Roelofs, K.G.; Comstock, L.E. Type VI secretion systems of human gut Bacteroidales segregate into three genetic architectures, two of which are contained on mobile genetic elements. BMC Genom. 2016, 17, 58. [Google Scholar] [CrossRef] [Green Version]
- Browne, K.; Kuppusamy, R.; Chen, R.; Willcox, M.D.P.; Walsh, W.R.; Black, D.S.; Kumar, N. Bioinspired Polydopamine Coatings Facilitate Attachment of Antimicrobial Peptidomimetics with Broad-Spectrum Antibacterial Activity. Int. J. Mol. Sci. 2022, 23, 2952. [Google Scholar] [CrossRef] [PubMed]
- Kittredge, H.A.; Dougherty, K.M.; Evans, S.E. Dead but Not Forgotten: How Extracellular DNA, Moisture, and Space Modulate the Horizontal Transfer of Extracellular Antibiotic Resistance Genes in Soil. Appl. Environ. Microbiol. 2022, 88, e0228021. [Google Scholar] [CrossRef] [PubMed]
- Matsui, K.; Ishii, N.; Kawabata, Z. Microbial interactions affecting the natural transformation of Bacillus subtilis in a model aquatic ecosystem. FEMS Microbiol. Ecol. 2003, 45, 211–218. [Google Scholar] [CrossRef]
- Burton, A.T.; Kearns, D.B. The Large pBS32/pLS32 Plasmid of Ancestral Bacillus subtilis. J. Bacteriol. 2020, 202, e00290-20. [Google Scholar] [CrossRef]
- Sun, D. Pull in and Push Out: Mechanisms of Horizontal Gene Transfer in Bacteria. Front. Microbiol. 2018, 9, 2154. [Google Scholar] [CrossRef]
- Hasegawa, H.; Suzuki, E.; Maeda, S. Horizontal Plasmid Transfer by Transformation in Escherichia coli: Environmental Factors and Possible Mechanisms. Front. Microbiol. 2018, 9, 2365. [Google Scholar] [CrossRef] [Green Version]
- Goers, L.; Freemont, P.; Polizzi, K.M. Co-culture systems and technologies: Taking synthetic biology to the next level. J. R. Soc. Interface 2014, 11, 20140065. [Google Scholar] [CrossRef] [Green Version]
- Joint, I.; Mühling, M.; Querellou, J. Culturing marine bacteria—An essential prerequisite for biodiscovery. Microb. Biotechnol. 2010, 3, 564–575. [Google Scholar] [CrossRef] [PubMed] [Green Version]
- Eskova, A.I.; Yakovlev, A.A.; Kim, A.V. Modeling of Interspecific Interaction of Yersinia pseudotuberculosis and Listeria monocytogenes in a Mixed-Species Biofilms with Microorganisms Isolated from Coastal Waters of the Sea of Japan. Bull. Exp. Biol. Med. 2021, 170, 471–474. [Google Scholar] [CrossRef] [PubMed]
- Yakovlev, A.A.; Rakov, A.V.; Pozdeeva, E.S. Significance of interspecies and intraspecies interactions of microorganisms as a sub-organism level in the hierarchy of the epidemic process. Epidemiol. Infect. Dis. 2020, 25, 118–130. [Google Scholar] [CrossRef]
- Jones, G.S.; D’Orazio, S.E. Listeria monocytogenes: Cultivation and Laboratory Maintenance. Curr. Protoc. Microbiol. 2013, 31, 9B.2.1–9B.2.7. [Google Scholar] [CrossRef] [PubMed] [Green Version]
- Garrity, G.M.; Brenner, D.J.; Krieg, N.R.; Staley, J.R.; Manual, B.S. 2. The Proteobacteria, Part B: The Gammaproteobacteria. In Bergey’s Manual of Systematic Bacteriology; Garrity, G., Brenner, D.J., Krieg, N.R., Staley, J.R., Eds.; Springer: Berlin/Heidelberg, Germany, 2005. [Google Scholar]
- Fukushima, H.; Gomyoda, M. Growth of Yersinia pseudotuberculosis and Yersinia enterocolitica biotype 3B serotype O3 inhibited on cefsulodin-Irgasan-novobiocin agar. J. Clin. Microbiol. 1986, 24, 116–120. [Google Scholar] [CrossRef] [Green Version]
- Speare, L.; Woo, M.; Dunn, A.K.; Septer, A.N. A Putative Lipoprotein Mediates Cell-Cell Contact for Type VI Secretion System-Dependent Killing of Specific Competitors. mBio 2022, 13, e0308521. [Google Scholar] [CrossRef]
- Landrigan, P.J.; Stegeman, J.J.; Fleming, L.E.; Allemand, D.; Anderson, D.M.; Backer, L.C.; Brucker-Davis, F.; Chevalier, N.; Corra, L.; Czerucka, D.; et al. Human Health and Ocean Pollution. Ann. Glob. Health 2020, 86, 151. [Google Scholar] [CrossRef]
- Tan, S.Y.; Dutta, A.; Jakubovics, N.S.; Ang, M.Y.; Siow, C.C.; Mutha, N.V.; Heydari, H.; Wee, W.Y.; Wong, G.J.; Choo, S.W. YersiniaBase: A genomic resource and analysis platform for comparative analysis of Yersinia. BMC Bioinform. 2015, 16, 9. [Google Scholar] [CrossRef] [Green Version]
- Konieczny, M.; Rhein, P.; Czaczyk, K.; Białas, W.; Juzwa, W. Imaging Flow Cytometry to Study Biofilm-Associated Microbial Aggregates. Molecules 2021, 26, 7096. [Google Scholar] [CrossRef]
- Deng, Y.; Xu, H.; Su, Y.; Liu, S.; Xu, L.; Guo, Z.; Wu, J.; Cheng, C.; Feng, J. Horizontal gene transfer contributes to virulence and antibiotic resistance of Vibrio harveyi 345 based on complete genome sequence analysis. BMC Genom. 2019, 20, 761. [Google Scholar] [CrossRef] [Green Version]
- Lasa, I.; Del Pozo, J.L.; Leiva, J.; Penadés, J.R. Bacterial biofilms and infection. An. Sist. Sanit. Navar. 2005, 28, 163–175. [Google Scholar] [CrossRef]
- Brilis, V.I.; Brilene, T.A.; Lentsner, K.P.; Lentsner, A.A. Metodika izucheniya adgezivnogo processa mikroorganizmov. Lab. Delo 1986, 4, 210–215. [Google Scholar]
- Tolker-Nielsen, T. Pseudomonas aeruginosa biofilm infections: From molecular biofilm biology to new treatment possibilities. APMIS Suppl. 2014, 122, 1–51. [Google Scholar] [CrossRef] [PubMed]
- Giaouris, E.; Heir, E.; Desvaux, M.; Hébraud, M.; Møretrø, T.; Langsrud, S.; Doulgeraki, A.; Nychas, G.-J.; Kačániová, M.; Czaczyk, K.; et al. Intra- and inter-species interactions within biofilms of important foodborne bacterial pathogens. Front. Microbiol. 2015, 6, 841. [Google Scholar] [CrossRef] [PubMed]
- Bukharin, O.V. Symbiotic Interactions of Microorganisms During Infenction. Mikrobiol. Epidemiol. Immunobiol. 2013, 1, 93–97. [Google Scholar]
- Terekhova, V.E.; Sosnin, V.A.; Buzoleva, L.S.; Shakirov, R.B. Distribution of the bacteria Listeria monocytogenes in the western part of the Sea of Okhotsk. Oceanology 2010, 50, 209–214. [Google Scholar] [CrossRef]
- Pushkareva, V.I.; Ermolaeva, S.A. Experimental Evidences On A Crop Plant Role In Epidemiology Of Sapronotic (Soil-Borne) Bacterial Infections. J. Microbiol. Epidemiol. Immunobiol. 2018, 5, 113–121. [Google Scholar] [CrossRef]
- Falardeau, J.; Walji, K.; Haure, M.; Fong, K.; Taylor, G.; Ma, Y.; Smukler, S.; Wang, S.; Taylor, G. ANative bacterial communities and Listeria monocytogenes survival in soils collected from the Lower Mainland of British Columbia, Canada. Can. J. Microbiol. 2018, 64, 695–705. [Google Scholar] [CrossRef]
- Huang, Z.; Mo, S.; Yan, L.; Wei, X.; Huang, Y.; Zhang, L.; Zhang, S.; Liu, J.; Xiao, Q.; Lin, H.; et al. A Simple Culture Method Enhances the Recovery of Culturable Actinobacteria From Coastal Sediments. Front. Microbiol. 2021, 12, 675048. [Google Scholar] [CrossRef]
- Cleland, C.E. Epistemological issues in the study of microbial life: Alternative terran biospheres? Stud. Hist. Philos. Sci. Part C Stud. Hist. Philos. Biol. Biomed. Sci. 2007, 38, 847–861. [Google Scholar] [CrossRef]
- Yunusova, I.O.; Yakovlev, A.A. The role of metabolites in the interspecific interaction of bacteria (review). Sanit. Dr. 2021, 8, 26–33. [Google Scholar] [CrossRef]
- Costerton, J.W.; Stewart, P.S.; Greenberg, E.P. Bacterial Biofilms: A Common Cause of Persistent Infections. Science 1999, 284, 1318–1322. [Google Scholar] [CrossRef] [PubMed] [Green Version]
- Juhas, M.; van der Meer, J.R.; Gaillard, M.; Harding, R.M.; Hood, D.W.; Crook, D.W. Genomic islands: Tools of bacterial horizontal gene transfer and evolution. FEMS Microbiol. Rev. 2009, 33, 376–393. [Google Scholar] [CrossRef] [PubMed] [Green Version]
- Norman, A.; Hansen, L.H.; Sørensen, S.J. Conjugative plasmids: Vessels of the communal gene pool. Philos. Trans. R. Soc. B Biol. Sci. 2009, 364, 2275–2289. [Google Scholar] [CrossRef] [Green Version]
- Schmidt, H.; Hensel, M. Pathogenicity Islands in BacterialPathogenesis. Clin. Microbiol. Rev. 2004, 17, 14–56. [Google Scholar] [CrossRef] [Green Version]
- Carniel, E. The Yersinia high-pathogenicity island: An iron-uptake island. Microbes Infect. 2001, 3, 561–569. [Google Scholar] [CrossRef]
- Kurpas, M.; Osek, J.; Moura, A.; Leclercq, A.; Lecuit, M.; Wieczorek, K. Genomic Characterization of Listeria monocytogenes Isolated From Ready-to-Eat Meat and Meat Processing Environments in Poland. Front. Microbiol. 2020, 11, 1412. [Google Scholar] [CrossRef]
- Jung, H. Hyaluronidase: An overview of its properties, applications, and side effects. Arch. Plast. Surg. 2020, 47, 297–300. [Google Scholar] [CrossRef]
- Yu, G.; Sun, Y.; Han, H.; Yan, X.; Wang, Y.; Ge, X.; Qiao, B.; Tan, L. Coculture, An Efficient Biotechnology for Mining the Biosynthesis Potential of Macrofungi via Interspecies Interactions. Front. Microbiol. 2021, 12, 663924. [Google Scholar] [CrossRef]
- Xu, X.-Y.; Shen, X.-T.; Yuan, X.-J.; Zhou, Y.-M.; Fan, H.; Zhu, L.-P.; Du, F.-Y.; Sadilek, M.; Yang, J.; Qiao, B.; et al. Metabolomics Investigation of an Association of Induced Features and Corresponding Fungus during the Co-culture of Trametes versicolor and Ganoderma applanatum. Front. Microbiol. 2018, 8, 2647. [Google Scholar] [CrossRef] [Green Version]
- Shen, X.-T.; Mo, X.-H.; Zhu, L.-P.; Tan, L.-L.; Du, F.-Y.; Wang, Q.-W.; Zhou, Y.-M.; Yuan, X.-J.; Qiao, B.; Yang, S. Unusual and Highly Bioactive Sesterterpenes Synthesized by Pleurotus ostreatus during Coculture with Trametes robiniophila Murr. Appl. Environ. Microbiol. 2019, 85, e00293-19. [Google Scholar] [CrossRef] [PubMed] [Green Version]
- Salomon, D.; Klimko, J.A.; Trudgian, D.C.; Kinch, L.; Grishin, N.V.; Mirzaei, H.; Orth, K. Type VI Secretion System Toxins Horizontally Shared between Marine Bacteria. PLoS Pathog. 2015, 11, e1005128. [Google Scholar] [CrossRef] [Green Version]
- Kempnich, M.W.; Sison-Mangus, M.P. Presence and abundance of bacteria with the Type VI secretion system in a coastal environment and in the global oceans. PLoS ONE 2020, 15, e0244217. [Google Scholar] [CrossRef] [PubMed]
- Gallegos-Monterrosa, R.; Coulthurst, S.J. The ecological impact of a bacterial weapon: Microbial interactions and the Type VI secretion system. FEMS Microbiol. Rev. 2021, 45, fuab033. [Google Scholar] [CrossRef] [PubMed]

Publisher’s Note: MDPI stays neutral with regard to jurisdictional claims in published maps and institutional affiliations. |
© 2022 by the authors. Licensee MDPI, Basel, Switzerland. This article is an open access article distributed under the terms and conditions of the Creative Commons Attribution (CC BY) license (https://creativecommons.org/licenses/by/4.0/).
Share and Cite
Eskova, A.I.; Andryukov, B.G.; Yakovlev, A.A.; Kim, A.V.; Ponomareva, A.L.; Obuhova, V.S. Horizontal Transfer of Virulence Factors by Pathogenic Enterobacteria to Marine Saprotrophic Bacteria during Co-Cultivation in Biofilm. BioTech 2022, 11, 17. https://doi.org/10.3390/biotech11020017
Eskova AI, Andryukov BG, Yakovlev AA, Kim AV, Ponomareva AL, Obuhova VS. Horizontal Transfer of Virulence Factors by Pathogenic Enterobacteria to Marine Saprotrophic Bacteria during Co-Cultivation in Biofilm. BioTech. 2022; 11(2):17. https://doi.org/10.3390/biotech11020017
Chicago/Turabian StyleEskova, Alena I., Boris G. Andryukov, Anatoli A. Yakovlev, Alexandra V. Kim, Anna L. Ponomareva, and Vera S. Obuhova. 2022. "Horizontal Transfer of Virulence Factors by Pathogenic Enterobacteria to Marine Saprotrophic Bacteria during Co-Cultivation in Biofilm" BioTech 11, no. 2: 17. https://doi.org/10.3390/biotech11020017
APA StyleEskova, A. I., Andryukov, B. G., Yakovlev, A. A., Kim, A. V., Ponomareva, A. L., & Obuhova, V. S. (2022). Horizontal Transfer of Virulence Factors by Pathogenic Enterobacteria to Marine Saprotrophic Bacteria during Co-Cultivation in Biofilm. BioTech, 11(2), 17. https://doi.org/10.3390/biotech11020017

